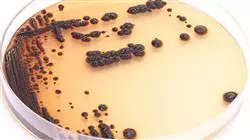
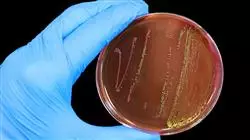

Diplôme universitaire
La plus grande faculté de médecine du monde”
Présentation
Grâce à ce Certificat 100% en ligne, vous acquerrez une compréhension approfondie de l'épidémiologie, de la pathogénie, de l'évaluation clinique et du traitement des Bactéries Multirésistantes à Gram Négatif”

Avec une capacité inhérente à développer une résistance à plusieurs classes d'antibiotiques, les Bactéries Gram Négatives Multirésistantes possèdent des mécanismes tels que la production de bêta-lactamases à spectre étendu et de carbapénémases, qui limitent considérablement les options thérapeutiques disponibles. Ce problème est particulièrement préoccupant dans les hôpitaux et les centres de soins intensifs, où les Infections Nosocomiales peuvent être difficiles à traiter.
C'est ainsi qu'est né ce Certificat, qui se penchera sur l'épidémiologie de ces micro-organismes, en soulignant leur prévalence croissante, à la fois dans les infections communautaires et nosocomiales. L'importance critique de ces infections en raison de leur capacité à résister à plusieurs antibiotiques, ce qui limite les options thérapeutiques disponibles et augmente la morbidité et la mortalité des patients affectés, sera également discutée.
La pathogenèse des infections à Gram Négatif Bactéries Multirésistantes sera également abordée, en examinant les facteurs de virulence et les éléments de l'hôte qui peuvent influencer la gravité de la maladie. En outre, d'autres facteurs environnementaux et liés au traitement qui peuvent moduler la progression de ces infections seront explorés.
Enfin, l'évaluation clinique détaillée des patients affectés par ces bactéries sera abordée, depuis l'anamnèse initiale jusqu'à l'utilisation d'examens complémentaires tels que les tests sanguins, l'imagerie diagnostique et les techniques microbiologiques avancées. Les outils actuels et émergents pour estimer la gravité des infections, ainsi que les facteurs de risque associés à l'acquisition de Bactéries Gram Négatives Multirésistantes, seront également abordés.
TECH a ainsi conçu un programme complet, entièrement en ligne et flexible, qui aidera les étudiants à éviter des problèmes tels que la nécessité de se rendre dans un centre physique ou de s'adapter à un emploi du temps préétabli. En ce sens, les diplômés n'auront besoin que d'un appareil électronique doté d'une connexion Internet pour accéder au matériel pédagogique et aux ressources multimédias. En outre, le diplôme est basé sur la méthodologie d'apprentissage révolutionnaire du Relearning, pionnière dans l'université, qui consiste en la répétition de concepts clés pour une assimilation optimale et organique de tout le contenu.
Vous vous familiariserez avec les dernières recherches et technologies en matière de Microbiologie et de maladies infectieuses, et développerez des compétences essentielles dans la prise en charge intégrée des patients concernés. Qu'attendez-vous pour vous inscrire?”
Ce Certificat en Bactéries Gram Négatives Multirésistantes contient le programme scientifique le plus complet et le plus actualisé du marché. Ses caractéristiques sont les suivantes:
- Le développement de cas pratiques présentés par des experts en Microbiologie, Médecine et Parasitologie
- Les contenus graphiques, schématiques et éminemment pratiques avec lesquels ils sont conçus fournissent des informations scientifiques et sanitaires essentielles à la pratique professionnelle
- Des exercices pratiques où effectuer le processus d’auto-évaluation pour améliorer l’apprentissage
- Il met l'accent sur les méthodologies innovantes
- Cours théoriques, questions à l'expert, forums de discussion sur des sujets controversés et travail de réflexion individuel
- La possibilité d'accéder aux contenus depuis n'importe quel appareil fixe ou portable doté d'une connexion internet
Vous aborderez l'évaluation clinique complète des patients atteints d'infections à Bactéries Gram Négatives Multirésistantes, en soulignant l'importance d'une anamnèse détaillée et de l'application de tests complémentaires”
Le corps enseignant du programme englobe des spécialistes réputés dans le domaine et qui apportent à ce programme l'expérience de leur travail, ainsi que des spécialistes reconnus dans de grandes sociétés et des universités prestigieuses.
Grâce à son contenu multimédia développé avec les dernières technologies éducatives, les spécialistes bénéficieront d’un apprentissage situé et contextuel, c'est-à-dire un environnement simulé qui fournira une formation immersive programmée pour s'entraîner dans des situations réelles.
La conception de ce programme est axée sur l'Apprentissage par les Problèmes, grâce auquel le professionnel doit essayer de résoudre les différentes situations de la pratique professionnelle qui se présentent tout au long du programme académique. Pour ce faire, l’étudiant sera assisté d'un innovant système de vidéos interactives, créé par des experts reconnus.
Vous analyserez les caractéristiques épidémiologiques des Bactéries Multirésistantes à Gram Négatif, en soulignant leur impact dans les milieux communautaires et nosocomiaux. Avec toutes les garanties de qualité TECH!"

Vous approfondirez d'autres éléments qui contribuent à la virulence et à la résistance des Bactéries Gram Négatives Multirésistantes, grâce aux meilleurs matériels pédagogiques, à la pointe de l'éducation et de la technologie"
Programme d'études
Ce Certificat comprendra une exploration détaillée de l'épidémiologie des infections causées par des Bactéries Gram Négatives Multirésistantes, à la fois dans des environnements communautaires et nosocomiaux. La pathogenèse de ces bactéries sera également étudiée en profondeur, en analysant les facteurs clés liés à leur virulence et à leur résistance aux antibiotiques. En outre, le contenu couvrira l'évaluation clinique complète des patients affectés, les techniques de diagnostic avancées, les stratégies thérapeutiques empiriques et ciblées, ainsi que la gestion du risque d'acquisition et de propagation de ces infections résistantes.
Le Certificat en Bactéries Gram Négatives Multirésistantes couvrira un large éventail de sujets fondamentaux pour comprendre et gérer efficacement ces pathogènes critiques dans le cadre des soins de santé”
Module 1. Bactéries Gram Négatives Multirésistantes
1.1. Infections par des microorganismes à Gram négatif
1.1.1. Épidémiologie des microorganismes à Gram négatif
1.1.2. Infections communautaires et nosocomiales dues à des microorganismes à Gram négatif
1.1.3. Pertinence des infections par des micro-organismes à Gram négatif multirésistants
1.2. Pathogenèse des infections par des micro-organismes à Gram négatif
1.2.1. Facteurs liés aux micro-organismes à Gram négatif
1.2.2. Facteurs liés au patient dans les infections à Gram négatif
1.2.3. Autres facteurs dans les infections à Gram négatif
1.3. Évaluation clinique des patients atteints d'infections à Gram négatif multirésistantes
1.3.1. Anamnèse
1.3.2. Évaluation clinique des patients
1.3.3. Autres données pertinentes
1.4. Tests complémentaires dans les infections à Gram négatif multirésistantes
1.4.1. Tests sanguins
1.4.2. Tests d'imagerie
1.4.3. Techniques microbiologiques
1.5. Estimation de la gravité chez les patients atteints d'infections à Gram négatif multirésistantes Microorganismes multirésistants à Gram négatif
1.5.1. Approche traditionnelle de l'estimation de la gravité
1.5.2. Nouveaux outils d'estimation de la gravité
1.5.3. Conclusions pratiques
1.6. Risque de contracter des infections par des micro-organismes Gram négatif multirésistants
1.6.1. Facteurs cliniques dans l'acquisition d'infections multirésistantes à Gram négatif
1.6.2. Autres facteurs d'acquisition d'infections par des micro-organismes Gram négatif multirésistants
1.6.3. Outils d'estimation du risque de présence de micro-organismes à Gram négatif multirésistants
1.7. Traitement empirique en cas de suspicion d'infection par des micro-organismes à Gram négatif multirésistants
1.7.1. Micro-organismes impliqués en fonction de la localisation
1.7.2. Évaluation complète des patients soupçonnés d'être infectés par des microorganismes Gram négatif multirésistants
1.7.3. Sélection d'un traitement antibiotique empirique
1.8. Thérapie ciblée dans les infections par des microorganismes à Gram négatif multirésistants
1.8.1. Adaptation de l'antibiothérapie en fonction des résultats microbiologiques
1.8.2. Suivi des infections à Gram négatif multirésistantes
1.8.3. Effets secondaires les plus importants de l'antibiothérapie
1.9. Durée de l'antibiothérapie dans les infections dues à des microorganismes à Gram négatif multirésistants
1.9.1. Estimation de la durée de l'antibiothérapie dans les infections à micro-organismes Gram négatif multirésistants
1.9.2. Pertinence du contrôle de la focalisation dans les infections à Gram négatif multirésistantes
1.9.3. Considérations particulières liées à l'Antibiothérapie dans ces infections.Considérations particulières liées à l'Antibiothérapie dans ces infections
1.10. Équipes PROA pour les infections à Gram négatif multirésistantes
1.10.1. Équipes PROA: Histoire
1.10.2. Impact des équipes PROA sur le bon usage des traitements antibiotiques
1.10.3. Défi des équipes PROA dans le traitement des infections à Gram négatif multirésistantes
Cette approche complète vous préparera à relever les défis actuels et futurs de la gestion clinique et épidémiologique des Bactéries Gram Négatives Multirésistantes, soutenue par la méthodologie révolutionnaire du Relearning”
Certificat en Bactéries Gram Négatives Multirésistantes
Vous souhaitez acquérir des connaissances approfondies sur les bactéries à Gram négatif qui ont développé une résistance à plusieurs antibiotiques ? Vous êtes au bon endroit. À TECH Global University, vous trouverez un Certificat complet qui vous aidera à atteindre vos objectifs académiques. Ce programme, proposé à 100 % en ligne, permet d'acquérir une compréhension approfondie et des compétences pratiques essentielles pour relever le défi croissant des bactéries multirésistantes dans ce groupe spécifique. Pendant le cours, vous explorerez en profondeur les mécanismes de la résistance bactérienne dans les bactéries Gram-négatives, y compris les entérobactéries résistantes aux carbapénèmes (CRE) et les Pseudomonas aeruginosa multirésistants (MDR-PARMF), entre autres. En outre, les facteurs contribuant à la résistance, les stratégies de diagnostic avancées, les options de traitement optimales et les mesures de prévention visant à contrôler la propagation de ces infections difficiles à traiter seront abordés. L'une des caractéristiques exceptionnelles de ce diplôme est son approche pratique et fondée sur des preuves. Vous aurez l'occasion d'appliquer vos connaissances à des situations cliniques réelles par le biais d'études de cas, d'analyses de scénarios cliniques complexes et de simulations. Cela vous permettra de développer des compétences critiques en matière de prise de décision dans le domaine des soins de santé et de conception de stratégies de traitement personnalisées pour lutter efficacement contre les bactéries Gram négatives multirésistantes.
Obtenez un diplôme avec un Certificat en Bactéries Gram Négatives Multirésistantes
Le mode en ligne du programme offre flexibilité et accessibilité, vous permettant d'accéder au contenu depuis n'importe quel endroit et à n'importe quel moment. Grâce à une plateforme éducative avancée, vous bénéficierez de ressources interactives et de matériel d'étude actualisé, ce qui enrichira considérablement votre expérience d'apprentissage. Le programme est dirigé par une équipe de professionnels ayant une grande expérience dans la gestion des bactéries Gram négatives multirésistantes, qui fournissent des conseils d'experts et un soutien continu tout au long du programme. Leur expérience clinique et leurs connaissances actualisées garantissent que vous recevrez une formation de haute qualité et pertinente pour répondre aux défis émergents dans ce domaine critique de la médecine. S'inscrire à ce Certificat est une décision stratégique pour exceller dans la gestion clinique des infections bactériennes complexes. Cette formation avancée fournit les outils nécessaires pour développer des stratégies efficaces de contrôle et de prévention des bactéries Gram négatives multirésistantes, contribuant ainsi à l'amélioration de la qualité des soins de santé et de la sécurité des patients.